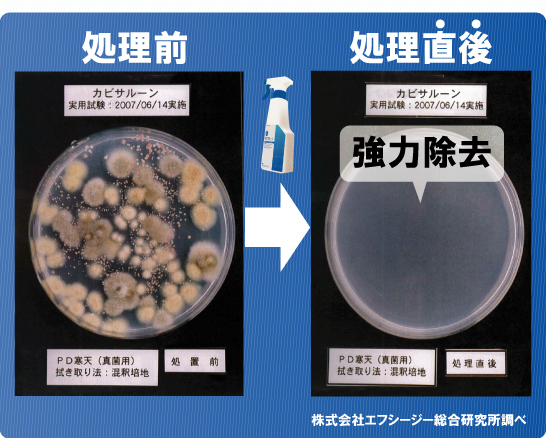
�J�r������������

カビサルーン | カビ取り剤・防カビ剤
「カビサルーン」カビ対策は非塩素系カビ取り剤
カビサルーンはカビ対策・処理に優れた効果を発揮するカビ取り・防カビ剤です。結露によるカビの発生防止にも有効です。カビが増殖する原因物質を破壊し、除去するカビ取り剤(カビを99%以上除去)。使用する面の汚れを落とし、本品をスプレーしてスポンジ、ブラシなどでこすり水洗い掃除するだけなので取り扱いも簡単。カビが発生しやすいバス、トイレ、キッチン、洗面所などの水周りや、エアコン、下駄箱、タイル目地、床や天井など、さまざまな場所へご使用いただけます。
特徴@…非塩素系 -ツンとしたイヤな臭いが激減-
カビサルーンは、非塩素系(弱酸性)液体なので、塩素系のカビ取り剤特有のあのツンと鼻をつく嫌な臭いがほとんどありません(※)。水で洗い流せば臭いは無くなります。※臭いはやわらげていますが、作業時は換気をよく行なってください。
特徴A…強力なカビ除去能力 (除去率:約99%)
カビサルーンはカビ除去力も極めて強力です。
特徴B…カビの繁殖を抑制(カビ対策) (2〜3週間)
普段、風呂場や洗面所などのカビを掃除した後、2〜3日するとまたカビが発生していませんか?その原因はカビの胞子です。胞子を根こそぎ除去しないとカビはすぐに発生します。 カビサルーンは、カビを除去した後、乾燥させた面やカビ発生を防止したい乾いた面にスプレーし、刷毛やスポンジでムラのないように広げるだけで、約2〜3週間、カビの繁殖を抑制することができます。

![]() トイレに |
![]() お風呂に |
![]() 洗面台に |
![]() エアコンに |
質問と答え カビサルーンについて
| 原液で使うのですか?薄めるのですか? | |
| そのまま原液でご使用下さい。 | |
|
|
|
| 茶色く変色しているけど、大丈夫ですか? | |
| はい。本商品は、2、3ヶ月保管しますと、色が茶色っぽく変色しますが、効果に問題はございませんので、安心してご使用下さい。
【ご注意】成分が沈殿している可能性が御座いますので、ご使用前にボトルをよく振ってお使い下さい。 |
|
| においがきついです。 | |
| カビサルーンは、非塩素系ですので塩素のツンとくる臭いは御座いませんが、薬品特有の臭いは確かに御座います。 ご使用の際は換気をしてください。ただし、人体に害は御座いませんのでご安心ください。 | |
| スプレー部分がくるくる回って使いにくいのですが… | |
| スプレーヘッドの赤いキャップを 通常よりもきつく締めて頂くと、ヘッドがきつく締まります。 | |
| キッチンで使用して、気化したものが引火したりしないの? | |
| 可燃性は一切ございません。 | |
| 畳にも使用していいの? | |
| はい。畳に吹きかけてカビを落とした後は、 固くしぼった雑巾などでよくふき取って頂ければ大丈夫です。 | |
販売終了
製品仕様
| 品名: | 家庭用カビ取り剤 |
| 品番: | DKS01 |
| 成分: | フェノール、フェニルフェノール、1-3プロパンジアミン、コハク酸、精製水 |
| 用途: | 家庭用(浴室、洗面所、浴槽、流し) |
| 標準使用量: | 1u当たり約15スプレー |
| 液性: | 弱酸性 |
| 正味量: | 2000ml |
| 付属品: | スプレー用詰め替えボトル・漏斗 |
| サイズ: | 本体… 21.5×14.5×奥行 8.5cm スプレーボトル… 22.5×7×奥行 4cm |
| 原産国: | アメリカ |
| 特許: | 米国特許:No.20020064544 EPA 69658-3 FDA K961044 |
| JAN: | 4529214010941 |
| 使用上の注意: |
|
スマホがアクションカメラに。パーツを組み合わせて、水中自撮りや車・自転車に取付けての撮影などができます。
花粉・ウイルス・PM2.5etc..を除去します。充電式、無音、無臭、軽量。
排水管つまりの原因も髪の毛・ゴミをごっそり除去!
手全体を掃除用スポンジ化できる便利な手袋型スポンジ。
防災用発電式ライト。官公庁も正式採用するナイトスターシリーズ新型機。
ボタンを押している間だけ飲み口が開き、指を離せば自動で閉まる保温マグ。
単3電池を単1電池として使える「電池スペーサー」単3電池1本で2本でも使える緊急対策グッズ。
水を含ますだけで冷感が長時間持続するネッククーラー。節電中も快適生活。
ファンの送風とミストで急速冷感。「気化熱」の仕組みを利用した画期的なウォーターミストクーラー。
ファンの送風とミストで急速冷感。コンパクトなミスト付小型携帯扇風機。
シロッコファンで上向き送風!首元涼しい!!
ミスト機能内蔵スクイーズボトル!水分補給とミスト冷却がこれ1本。熱中症対策にも。
乾電池も使える小型扇風機「マイファンポータブル」サブ扇風機やサーキュレーターとしても活躍します。
お好みの歯ブラシが電動歯ブラシに!!
目に見えない排水口のお掃除を簡単・安全に出来る。
野菜の水洗い〜水切り、米洗い可能。新型サラダスピナー。
ハンディ型エスプレッソマシン。手軽にご家庭やアウトドアでも気軽に本格エスプレッソを楽しめます。
多くのメーカー・機種に対応するデジカメ用防水パックです。ズームレンズにも対応します。
iPhone・スマートフォン専用の防水パックです。2種類のサイズで各メーカー・機種に対応。通話、メールも可能です。
自動でビンのフタを開封してくれる電動ワンタッチビンオープナー。
自動で缶詰を開封してくれるワンタッチ缶オープナー。
上下にスパイスが入る電動ミル。片手で簡単に2種類のスパイスを切替え。
クイックプレスに洋服を乗せてパタパタと折り込めば、誰でも簡単に素早くキレイに畳めます。
ワンタッチで着脱可能な折りたたみ式ハンガー。肩幅の調整も自由自在!
ツンとした臭いが無く、強力なカビ除去が可能。カビの発生を抑制。
漁業用探知機の技術を手の平サイズにまでコンパクト化した超軽量設計の魚探。
プロも愛用する携帯用ゴルフボールクリーナー。セルフプレーに。
シャワーモードを自在に調整できるシャワーヘッド。止水レバー付&節水効果も。
衣類圧縮袋「EZパック」丈夫で長持ち、ファスナーいらずの特殊設計。







































